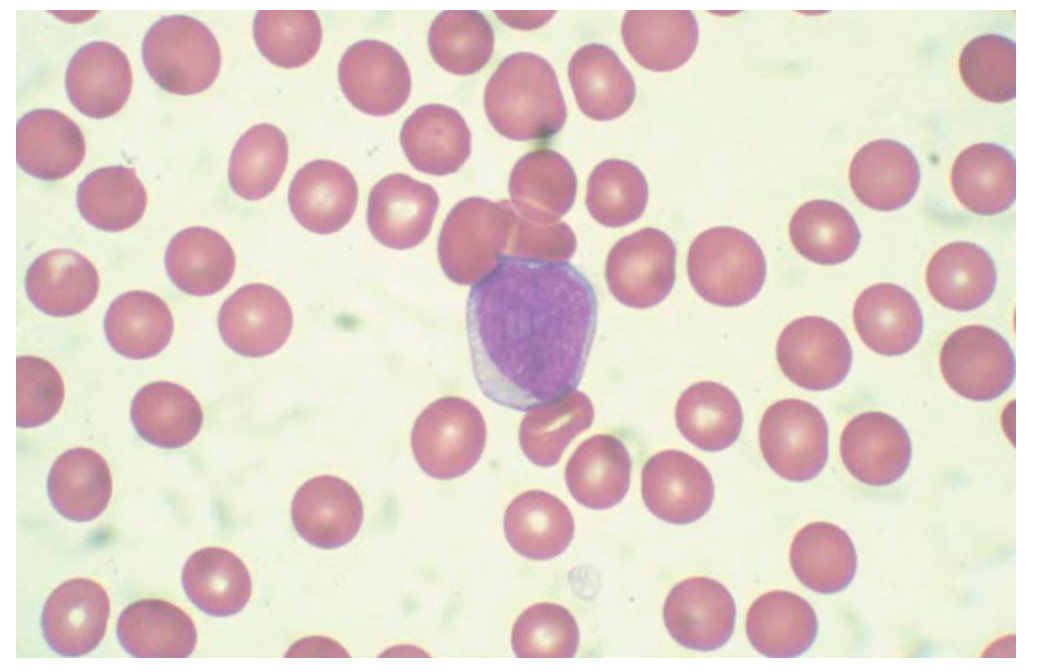
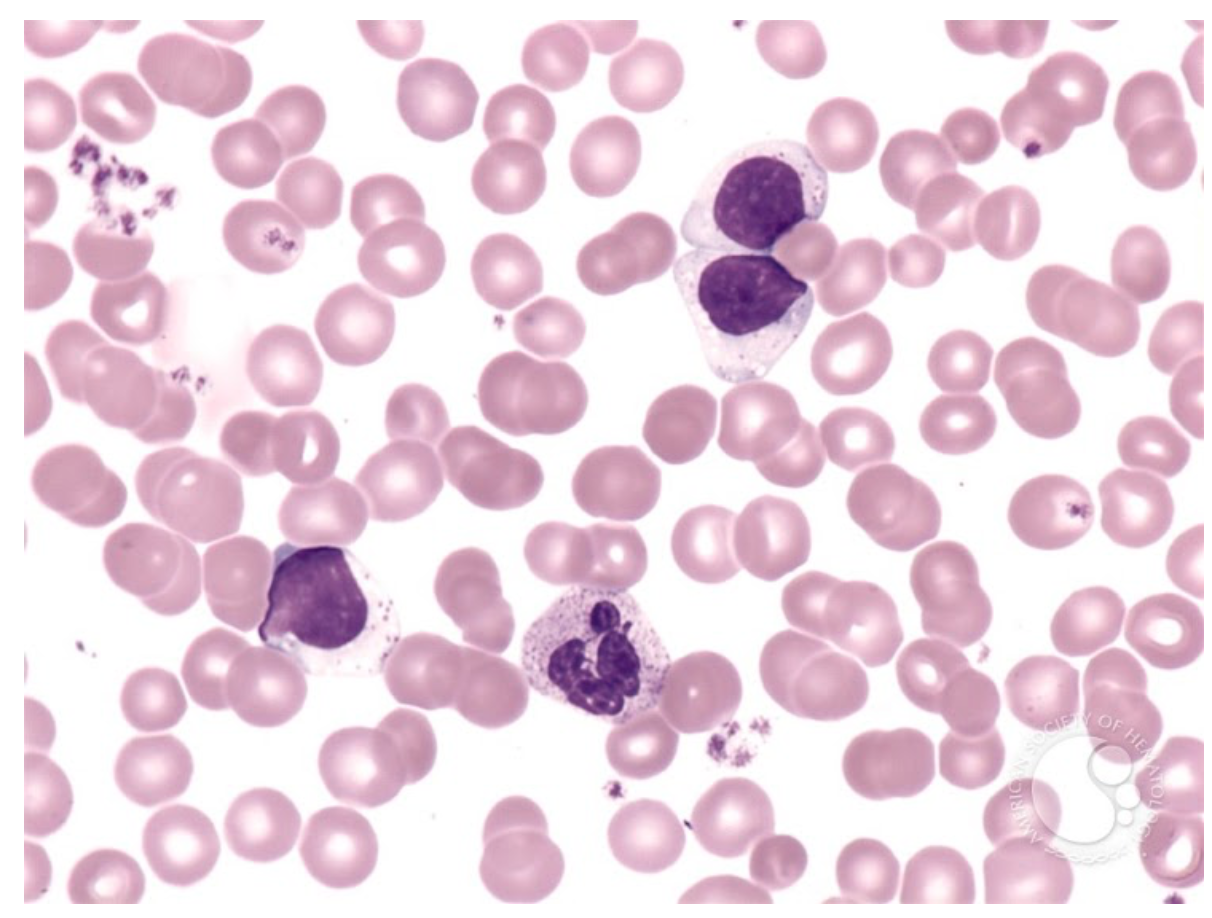

Qual benefício NÃO é esperado com uso de Ruxolitinib em pacientes portadores de mielofibrose avançada?
A) Redução da esplenomegalia
B) Menor taxa de progressão para LMA
C) Aumento de sobrevida global
D) Maior incidência de plaquetopenia
B) MENOR TAXA DE PROGRESSÃO PARA LMA
O estudo CONFORT-I foi um estudo duplo cego, randomizado e controlado que comparou o uso de Ruxolitinib versus placebo em pacientes portadores de mielofibrose primária ou secundária avançada (definido como risco intermediário-2 ou alto pelo score IPSS) E esplenomegalia.
Sabe-se que a maioria dos pacientes com mielofibrose apresenta desregulação da via de sinalização da Janus Kinase (JAK/STAT).
As frequências das driver mutations relacionadas a esse fenômeno são: JAK2 (55-65%), CALR (15-25%) e MPL (5-15%). Além disso, 10-20% dos pacientes são triplo negativos para essas mutações.
Neste estudo, a dose inicial de Ruxolitinib variou conforme a contagem de plaquetas:
O desfecho primário foi a taxa de redução do volume esplênico em pelo menos 35% após 24 semanas de tratamento.
Os desfechos secundários foram a duração da resposta esplênica e a sobrevida global.
No grupo que recebeu Ruxolitinib, 59% alcançou a redução esperada do volume esplênico, com mediana de duração de resposta de 42 meses.
Na análise em 5 anos, não houve diferença de sobrevida global em relação ao grupo placebo, entretanto, o estudo permitiu CROSSOVER após sua fase inicial, o que resultou no uso de Ruxolitinib por 73% dos pacientes inicialmente randomizados para o grupo placebo.
Quando se analisa a sobrevida global censurando-se o grupo placebo no momento do crossover, observa-se redução de 30% no risco de mortalidade nos pacientes que utilizaram Ruxolitinib desde o começo do estudo.
Os efeitos adversos mais comuns foram anemia e plaquetopenia, sobretudo nos primeiros 6 meses de tratamento.
A taxa de progressão para leucemia mieloide aguda foi semelhante à história natural da doença em controles históricos, sugerindo que o uso do medicamento não protege contra a evolução clonal.
Homem, 55 anos, previamente hígido, admitido devido febre, dor óssea generalizada e astenia intensa há 7 dias. Exame físico sem alterações. Hb 5,2 g/dl, Neu 300 mg/dl e Plq 22 mil/mm³. Ultrassonografia de abdome: sem alterações. Esfregaço de sangue periférico mostrado abaixo. Aspirado de medula óssea seco. Biópsia de medula óssea mostrou hipercelularidade difusa às custas de expansão da série eritroide, granulocítica e megacariocítica, com frequentes micromegacariócitos. Foi identificada a presença de 25% de células imaturas com marcação positiva para CD45, CD34, CD33 e CD117 e negativa para mieloperoxidase. Avaliação do estroma revelou fibrose reticulínica grau 2. Neste caso, qual o diagnóstico mais provável?
A) Panmielose com mielofibrose
B) Leucemia megacarioblástica aguda
C) Mielofibrose primária transformada em LMA
D) PV transformada em LMA
PANMIELOSE COM MIELOFIBROSE
A panmielose aguda com mielofibrose é uma proliferação panmieloide aguda com aumento de blastos (≥ 20% na medula óssea e/ou sangue periférico) e presença de fibrose de QUALQUER grau na medula óssea.
Por definição, não pode preencher critérios para LMA com alterações genéticas recorrentes, LMA relacionada a alterações mielodisplásicas ou LMA relacionada à terapia.
Apresenta-se como quadro AGUDO caracterizado por sintomas constitucionais intensos, sobretudo astenia. Febre e dor óssea são comuns. Pancitopenia está SEMPRE presente.
NÃO há esplenomegalia, podendo eventualmente haver discreto aumento do baço.
No sangue periférico, observa-se série vermelha com discreta anisocitose e macrocitose variável. Entretanto, NÃO há presença de dacriócitos nem quantidade significativa de eritroblastos.
Pode haver presença de blastos circulantes, porém SEM desvio escalonado à esquerda.
O aspirado de medula óssea é frequentemente SECO.
Na biópsia de medula óssea, observa-se tecido medular hipercelular para a idade e displasia frequente, porém sem critérios para LMA relacionada a alterações mielodisplásicas.
O estroma é difusamente fibrótico (gravidade variável), observa-se AUMENTO dos precursores eritroides, granulocíticos e megacariocíticos, definindo o fenômeno de PANMIELOSE.
É comum a presença de megacariócitos displásicos, predominantemente de tamanho PEQUENO e com citoplasma eosinofílico, com atipia nuclear variável.
A maioria dos casos tem baixa carga de blastos, por volta de 20-25%.
A coloração para MIELOPEROXIDASE geralmente é NEGATIVA e o imunofenótipo é caracterizado pela presença de CD34 POSITIVO associado a pelo menos 1 dos seguintes marcadores: CD13, CD33 e/ou CD117, semelhante ao que se observa na LMA com diferenciação mínima.
Outro diagnóstico diferencial importante é a leucemia megacarioblástica aguda, porém neste caso, a infiltração por blastos seria mais PROEMINENTE, não haveria aumento das demais séries e a marcação imunohistoquímica seria negativa para CD45, CD34, CD33 e CD13 na maioria dos casos.
A resposta à quimioterapia é ruim e a sobrevida é de poucos meses.
Key Points:
Referências:
1. Swerdlow S, et al. WHO Classification of Tumours of Haematopoietic and Lymphoid Tissues. 2017.
Dentre os pacientes portadores de leucemia mieloide crônica que RESISTENTES ao tratamento de PRIMEIRA LINHA com Imatinib, qual a frequência de MUTAÇÃO do BCR-ABL1?
A) 10%
B) 100%
C) 50%
D) 25%
A) 50%
Os inibidores de tirosina quinase (TKI) utilizados no tratamento da leucemia mieloide crônica são drogas alvo relativamente específicas que atuam por inibição do DOMÍNIO TIROSINA QUINASE da proteína de fusão BCR-ABL1, formado pela t(9;22).
Alguns pacientes, entretanto, são RESISTENTES ao tratamento com TKI.
Nesses casos, o primeiro passo é verificar a ADESÃO ao tratamento, uma vez que, em se tratando de uma doença crônica, está sujeita à baixa adesão por necessidade de uso diário do medicamento por tempo indeterminado.
Após pesquisar adesão adequada, o próximo passo é confirmar a perda de resposta com NOVA QUANTIFICAÇÃO do BCR-ABL1, considerando que existe VARIABILIDADE significativa nos testes laboratoriais. Essa etapa se torna ainda mais importante no caso de pequenas flutuações ao redor do ponto de corte de 0,1%.
Confirmando-se a perda de resposta, o último passo é TROCAR o TKI e realizar em paralelo pesquisa de MUTAÇÃO no domínio tirosina quinase do BCR-ABL1, importante para orientar a escolha do melhor TKI de segunda linha.
Entretanto, somente cerca de METADE dos pacientes RESISTENTES ao uso de Imatinib em primeira linha apresenta mutação identificada no domínio tirosina quinase.
A outra metade dos pacientes provavelmente apresenta outras alterações genéticas que os tornam menos dependentes do BCR-ABL1 e, portanto, garantem a manutenção da doença apesar do bloqueio adequado da proteína de fusão. Esses clones resistentes são considerados menos “oncogene addicted” e tem potencial de evoluir para doença refratária.
Mesmo assim, a troca por outro TKI pode ser efetiva no controle da doença por mecanismos poucos esclarecidos.
Nesse contexto, o uso de novos INIBIDORES ALOSTÉRICOS do BCR-ABL1, como o Asciminib, tem sido explorados em combinação com os TKIs clássicos já disponíveis na prática clínica e parecem ser promissores.
Key Points:
Referências:
Mulher, 45 anos, portadora de leucemia mieloide crônica, assintomática, comparece para consulta de rotina. Hb 14,2 g/dl, GB 11.000/mm³, Neu 4.000/mm³, Ly 6.000/mm³ e Plq 180 mil/mm³. Pesquisa de BCR-ABL1 por RT-PCR: indetectável. Esfregaço de sangue periférico mostrado abaixo. Neste caso, qual TKI provavelmente está sendo utilizado?
A) Imatinib
B) Ponatinib
C) Dasatinib
D) Nilotinib
C) DASATINIB
Em situações normais, os linfócitos LGL (large granular lymphocytes) representam até 10-15% do total de células mononucleares no sangue periférico e constituem parte da imunidade adquirida contra infeções virais e neoplasias.
O aumento de linfócitos LGL pode significar expansão das populações de linfócitos T citotóxicos e/ou NK e ocorre em resposta a infecções virais, doenças autoimunes, neoplasias, imunodeficiências e após transplante de órgãos sólidos ou medula óssea alogênico.
Raramente, a proliferação de linfócitos LGL é clonal e representa neoplasia hematológica verdadeira.
O Dasatinib é um inibidor de tirosina quinase de segunda geração utilizado no tratamento de leucemia mieloide crônica e leucemia linfoblástica aguda que, além de seu efeito inibitório sobre a proteína de fusão BCR-ABL1, também possui capacidade de inibir várias outras moléculas com função quinase (como Src e Tec), não inibidas por outros TKIs com espectro de ação mais restrito.
A expansão de linfócitos LGL é frequente durante o uso de Dasatinib, com aumento tanto do fenótipo CD3+/CD8+ (célula T de memória efetora) quanto do fenótipo CD3-/CD16+/CD56+ (célula NK verdadeira).
O grau de linfocitose LGL é proporcional à dose do medicamento utilizada, pode ocorrer em qualquer momento do tratamento (sendo mais frequente nos primeiros meses) e desaparece rapidamente após interrupção da medicação.
Na avaliação de clonalidade, é comum haver rearranjo clonal do TCR, identificado em mais de 80% dos pacientes com linfocitose LGL em uso de Dasatinib.
Um dado interessante é a correlação entre resposta molecular profunda e a presença de linfocitose LGL, provavelmente por um efeito antineoplásico adicional promovido por essas células.
Da mesma forma, a frequência de efeitos adversos (como febre, derrame pleural e derrame pericárdico) associados ao uso de Dasatinib também é mais frequente nesse grupo de pacientes.
Key Points:
Referências:
Homem, 70 anos, encaminhado para avaliação devido astenia e leucocitose persistente há 4 meses. Hb 8,5 g/dl, GB 28.000/mm³, Neu 7.500/mm³, Monócitos 14.300/mm³ e Plq 102 mil/mm³. Exame físico identificou esplenomegalia volumosa. Mielograma evidenciou diseritropoese, disgranulopoese e presença de 8% de blastos. Biópsia de medula óssea mostrou tecido hematopoético hipercelular para a idade, aumento de células imaturas e ausência de fibrose reticulínica. Cariótipo de medula óssea: 46, XY [20]. Pesquisa de BCR-ABL1 por RT-PCR: negativa. Pesquisa de mutação da JAK2 V617F: negativa. Painel de NGS para neoplasias mieloides: presença de variante potencialmente patogênica do gene SRSF2 (VAF 28%). neste caso, qual o diagnóstico mais provável?
A) Síndrome mielodisplásica
B) Leucemia mieloide crônica atípica
C) Leucemia mielomonocítica crônica, variante proliferativa
D) Leucemia mielomonocítica crônica, variante displásica
C) LEUCEMIA MIELOMONOCÍTICA CRÔNICA, VARIANTE PROLIFERATIVA
No caso apresentado, temos um paciente idoso, com esplenomegalia, leucocitose, monocitose, displasia na medula óssea e excesso de blastos.
A primeira etapa diagnóstica consiste na EXCLUSÃO de leucemia mieloide crônica, descartada pela ausência do gene de fusão BCR-ABL1.
Além disso, a biópsia de medula óssea mostrou ausência de fibrose, desfavorendo o diagnóstico alternativo de mielofibrose.
O achado de monocitose relativa (≥10%) e absoluta (≥1000/mm³) em sangue periférico associado à displasia de pelo menos uma linhagem na medula óssea sugere o diagnóstico de leucemia mielomonocítica crônica (LMMC), desde que sejam descartadas outras entidades mais comuns, como as neoplasias mieloproliferativas.
Nesta condição, o número de blastos pode estar aumentado, desde que seja menor que 20%.
Cerca de 90% dos pacientes com LMMC apresentam alguma alteração clonal.
Os genes mais frequentemente mutados são: TET2 (50-60% dos casos), SRSF2 (40-50%), ASXL1, SETBP1, RUNX1, NRAS e CBL.
Portanto, o diagnóstico mais provável do caso apresentado é leucemia mielomonocítica crônica, variante proliferativa (definida pela contagem de glóbulos brancos maior ou igual a 13.000/mm³). Casos com contagem de glóbulos brancos inferior a 13.000 são classificados como variante displásica.
Key Points:
Referências:
Assinale a alternativa INCORRETA sobre a investigação de hipereosinofilia:
A) A hipereosinofilia é definida pela presença de mais de 1500 eosinófilos por mm3 no sangue periférico ou nas seguintes condições: infiltração patológica de tecidos por eosinófilos; > 20% de eosinófilos das células nucleadas da MO por mielograma; deposição acentuada de prote;inas de eosinófilos nos tecidos
B) A hipereosinofilia subtipo linfócito-variante geralmente apresenta curso agressivo, com prognóstico desfavorável, devendo considerar o TMO alogênico como tratamento definitivo nesses casos
C) A hipereosinofilia com mutação no FIP1L1-PDGFRA tem uma ótima resposta com doses baixas de imatinibe (100mg). Com variantes da mutação do PDGFRB e PDGFRA o uso de imatinibe deve ser aumentado para 400mg e mantém uma ótima resposta molecular, em torno de 96%
D) A hipereosinofilia associada a anormalidade do FGFR1 e PCM JAK2 geralmente evolui para LMA em 1-2 anos. Não há consenso quanto ao tratamento ideal para tais casos, porém a maioria dos pacientes apresenta resistência a quimioterapia, devendo considerar o TMO alogênico como tratamento definitivo
B) A hipereosinofilia subtipo linfócito-variante geralmente apresenta curso agressivo, com prognóstico desfavorável, devendo considerar o TMO alogênico como tratamento definitivo nesses casos
Comentário:
A síndrome hipereosinofílica é definida como eosinófilos > 1500 e evidencia de manifestações orgânicas atribuíveis a eosinofilia. Essas manifestações são: (A) Eosinófilos > 20% de células nucleares em MO; (B) Infiltração tecidual por eosinófilos; (C) Deposição extracelular de proteínas derivadas de eosinófilos nos tecidos. Portanto, a letra A está correta.
Desde 2005 um consenso internacional sobre o tratamento de SHE propôs um esquema que subdividiu pacientes em 6 grupos clinicamente definidos para ajudar em decisões relacionadas a tratamento: (A) SHE mieloproliferativa; (B) SHE variante linfocícita; (C) SHE overlap; (D) SHE associada/secundária; (E) SHE familiar e (F) SHE idiopática.
O subtipo variante linfocítica descrito na letra B está relacionado a SHE com uma população linfocitária clonar fenotipicamente aberrante produzindo citocinas que estimulam a eosinofilia. É caracterizada por ter um curso indolente com frequentes manifestações de pele e partes moles. No entanto, pode evoluir para linfoma/leucemia em até 25% dos casos no decorrer dos anos. Portanto, como a letra B afirma que essa variante tem um curso agressivo, torna a alternativa incorreta.
As letras C e D falam ambas do subtipo SHE mieloproliferativa. Esse subtipo é causado por um envolvimento de eosinófilos clonais. Estudos mais antigos mostram que alguns pacientes com SHE e achados clínicos sugestivos de doença mieloproliferativa (eosinofilia displasia, precursores mieloides circulantes, anemia, trombocitopenia, esplenomegalia, B12 elevado, triptase elevada) apresentam boa resposta a imatinib. Posteriormente percebeu-se que esses pacientes possuíam uma alteração citogenética com del4q12 causando uma tirosina kinase a ficar constitutivamente ativa (FIP1L1-PDGFRA) que pode ser detectado por FISH ou RT-PCR de sangue periférico ou MO. Esses pacientes devem ser tratados com imatinib 100-400mg/dia. No entanto, alguns pacientes que apresentam outras alterações que não a citada acima podem ter uma resposta subotima a terapia com ITK. Alguns desses pacientes tem um curso mais agressivo e essas anormalidades que estão associadas a resistência ao imatinib podem ser o FGFR1, sendo o tratamento incerto para esses pacientes.
(DASA PROVA 2023) Paciente de 58 anos assintomático e sem comorbidades, vem em consulta apresentando Hb de 9,6 normocítica e normocrômico, leucócitos de 12 mil com desvio até blastos, plaquetas de 92 mil, com esplenomegalia de 14 cm. Realizou mielograma que mostrava hipercelularidade com displasia da série granulocítica leve. Na biópsia de medula óssea mostrava hipercelularidade com atipias de megacariócitos e fibrose reticulinica grau 2. Cariótipo 46 XY Fish sem alterações. Paciente possui um irmão de 56 anos Hla identico e um doador no rereme hla identico de 22 anos. Em relação a este paciente: Qual o diagnóstico mais provável e amutação de baixo risco relacionado ao diagnostico?
Gabarito: Mielofibrose, mutaçao CALR
(DASA PROVA 2023) Paciente de 58 anos assintomático e sem comorbidades, vem em consulta apresentando Hb de 9,6 normocítica e normocrômico, leucócitos de 12 mil com desvio até blastos, plaquetas de 92 mil, com esplenomegalia de 14 cm. Realizou mielograma que mostrava hipercelularidade com displasia da série granulocítica leve. Na biópsia de medula óssea mostrava hipercelularidade com atipias de megacariócitos e fibrose reticulinica grau 2. Cariótipo 46 XY Fish sem alterações. Paciente possui um irmão de 56 anos Hla identico e um doador no rereme hla identico de 22 anos. Em relação a este paciente: Quais as mutações de alto risco relacionado a este diagnóstico:
Gabarito: ASXL1, EZH2, SRSF2, IDH1/2, U2AF1 ,
(DASA PROVA 2023) Paciente de 58 anos assintomático e sem comorbidades, vem em consulta apresentando Hb de 9,6 normocítica e normocrômico, leucócitos de 12 mil com desvio até blastos, plaquetas de 92 mil, com esplenomegalia de 14 cm. Realizou mielograma que mostrava hipercelularidade com displasia da série granulocítica leve. Na biópsia de medula óssea mostrava hipercelularidade com atipias de megacariócitos e fibrose reticulinica grau 2. Cariótipo 46 XY Fish sem alterações. Paciente possui um irmão de 56 anos Hla identico e um doador no rereme hla identico de 22 anos. Qual melhor doador para esse paciente? Justifique sua resposta:
Gabarito: Hla identico AP - primeira escolha ainda
(DASA PROVA 2023) Paciente de 58 anos assintomático e sem comorbidades, vem em consulta apresentando Hb de 9,6 normocítica e normocrômico, leucócitos de 12 mil com desvio até blastos, plaquetas de 92 mil, com esplenomegalia de 14 cm. Realizou mielograma que mostrava hipercelularidade com displasia da série granulocítica leve. Na biópsia de medula óssea mostrava hipercelularidade com atipias de megacariócitos e fibrose reticulinica grau 2. Cariótipo 46 XY Fish sem alterações. Paciente possui um irmão de 56 anos Hla identico e um doador no rereme hla identico de 22 anos. Foi indicado TMO alogênico. Descreva fonte, profilaxia de GVHD, condicionamento e tempo de imunossupressão nesse caso:
Gabarito: SP, flu bu 3 , cy pt , 70 dias retirada.
(HIAE 2022) Feminina, 54 anos, diagnóstico de (PV) JAK2 V617F+ há 5 anos. Procura uma segunda opinião com perda de 2 kg. Estava em tratamento com flebotomia periódica, a fim de manter HCT < 45%, que foi suspensa após normalização do hemograma há 6 meses. Ao exame físico: baço a 2 cm do rebordo costal esquerdo. Aos exames laboratoriais: Hb 10 g/dL, Pqt: 130 × 109/L e leuco: 15 × 109/L. A repetição do exame da medula óssea mostra nova fibrose grau 2 com citogenética normal. Realizado NGS que evidencia novas aberrações moleculares CarL R, SRSF2 e EZH2. Paciente tem um doador irmão HLA idêntico e 2 doadores HLA-haploidênticos.
(A) A presença de CarL R é um fator de mau prognóstico.
(B) O tratamento com inibidor de JAK2 está indicado.
(C) De acordo com a pontuação de risco MY-SEC para mielofibrose pós ET/PV, a sobrevida deve ser inferior a 1 ano.
(D) DIPSS/DIPSS plus e MIPSS70 são os modelos de pontuação de risco validados para mielofibrose primária.
(D) DIPSS/DIPSS plus e MIPSS70 são os modelos de pontuação de risco validados para mielofibrose primária
Trata-se de uma paciente com DMPC evoluindo com anemia e diminuição de necessidade der realização de flebotomias para controle de Ht. Além disso, apresenta surgimento de sintomas constitucionais e esplenomegalia, sendo obrigatório considerar a hipótese de progressão para mielôfibróse secundária. Para o diagnóstico de mielôfibróse secundária é necessário preenchimento dos critérios da imagem.
Para o manejo desse paciente é necessário estabelecimento do risco e prognóstico com os sistemas desenvolvidos para isso. Os cores utilizados para mielôfibróse primária são: DIPSS/DIPSS Plus, GIPSS, MYPSS70 OU MYPSS70+V2.0 - (LETRA D CORRETA). Os mesmos scores podem ser usados na mielôfibróse secundária, além do score desenvolvido especificamente para essa situação que é o MY-SEC. Além dos critérios dos scores estabalecidos, sabe-se que pacientes com mutação CALR tem um prognóstico mais favorável (LETRA A INCORRETA). Tanto que no calculo do MYSEC ou MYPSS70 a presença de CALR mutado diminui a pontuação do calculo e no caso dessa paciente. Caso fizessemos o calculo, o MYSEC seria intermediário-1, com OS esperada 9 anos (C INCORRETA). Existem diversos scores de predição de risco para PMF e MF secundária, conforme já dito. Dentre eles, prefere-se a utilização de scores que introduzam características de mutações e alterações moleculares, como o MYPSS70 ou MYPSS70+v2.0. Se utilizarmos o MYPSS70+v2.0 para estratificar esse paciente, pela presença de 2 mutações de alto risco (SRSF2 e EZH2) além das outras características, esse paciente seria classificado como alto risco. Dessa forma, por ter 54 anos, sem descrição de fatores de pior prognóstico ao TMO, com irmão HLA identico, indica-se TMO em primeira linha (B INCORRETA).
Obs.: Perceba como a conduta muda a depender do score de prognóstico utilizado. O MYSEC (sem utilizar critérios moleculares) classifica o paciente como int-1. Já o MYPSS70+2.0 (ideal) classifica como alto risco, mudando o tratamento. Mas podemos também utilizar o bom senso, de que essa paciente é jovem e eventualmente vai progredir para LMA (principal causa de morte nesses pacientes). Talvez esperar a evolução da doença leve a piora de PS e impossibilidade de TMO mais na frente.
(HIAE 2021) Com relação à Mielofibrose primária, é correto afirmar:
(A) O gene MPL é o gene mais frequentemente mutado na mielofibrose após o JAK2.
(B) Na maior parte dos pacientes (60% dos casos) não se encontra mutação, sendo chamados triplo-negativos, seguida da presença de JAK-V617R (20%).
(C) Até o momento, sabe-se que apenas os genes da via JAK-STAT desempenham papel prognóstico na mielofibrose.
(D) Achado de mutação em SRSF2 e IDH estão associados a menor risco de transformação leucêmica.
(E) Mutações do ASXL1 estão relacionadas a maior risco de transformação leucêmica.
(E) Mutações do ASXL1 estão relacionadas a maior risco de transformação leucêmica.
LETRA A e B - INCORRETAS: Quanto a driver mutations observadas na PMF, 90% dos pacientes apresentam pelo menos alguma (triplo negativos 8-10%). Quanto a frequência:
- JAK2: 60-65%
- CALR: 20-25%
- MPL: 5%
LETRA C - INCORRETA: Obviamente as driver mutations desempenham um papel no prognostico dos pacientes, com melhor OS nos pacientes com CALR e pior OS nos pacientes triplo negativos. No entanto, outras alterações moleculares também tem uma contribuição (ASXL1, SRSF2, U2AF1Q157…)
LETRA D - INCORRETA: Essas mutações moleculares trazem maior risco de evolução e progressão desses pacientes. Por exemplo, scores de estratificação de risco dos pacientes com PMF que incluem aspectos moleculares introduzem essas mutações (e sua quantidade) como critério.
LETRA E - CORRETA: Ao contrário da letra D, a presença de ASXL1 confere maior risco, sendo que estão presentes como critérios para estratificar esses pacientes como maior risco molecular e maiores taxas de progressão
(HIAE 2021) Sobre a mielofibrose primária, é correto:
(A) O tratamento independente do prognóstico é o transplante de medula óssea alogênico, mas seu fator limitante é a idade da maioria dos pacientes.
(B) Paciente com esplenomegalia apresenta pior prognóstico.
(C) A profilaxia antitrombótica deve ser de rotina para pacientes acima de 65 anos pelo elevado risco de trombose.
(D) A análise do NGS (next generation sequency) é essencial para o diagnóstico e prognóstico da doença.
(E) Um dos critérios diagnósticos é a exclusão de leucemia mieloide crônica Bcr abl+.
(E) Um dos critérios diagnósticos é a exclusão de leucemia mieloide crônica Bcr abl+
LETRA A - INCORRETA:
O tratamento de paciente com MF depende da estratificação de risco de progressão e gravidade do quadro, além da elegibilidade a TMO. A estratificação de risco é feita através de scores prognósticos diversos, sendo idealmente escolhidos os scores que levam em consideração aspectos moleculares. Os pacientes de alto risco e elegíveis ao TMO devem ser tratados com essa estratégia, com potencial benefício de cura e OS, sendo o benefício maior que sua potencial toxicidade. Nenhum estudo randomizado comparou essa abordagem, além disso, os estudos retrospectivos devem ser interpretados com cuidado pois em geral os pacientes transplantados são mais jovens e com tendencia a menor TRM no TMO. No entanto, em pacientes com estratificação de risco mais baixa o tratamento não deve incluir inicialmente TMO, com o direcionamento baseado para controle de sintomas. A morbimortalidade do TMO nesses pacientes supera os possíveis benefício do TMO, já que esse grupo já tem um melhor prognóstico (mediana OS > 5anos). Além disso, a idade deve ser considerada, mas não é um fator limitante para o TMO.
LETRA B - INCORRETA:
Existem diversos fatores prognósticos a serem considerados nesses pacientes, incluindo fatores clínicos, citogenéticos e moleculares. Dentre esses fatores clínicos, a esplenomegalia não faz parte. O que deve-se levar em consideração é em pacientes com esplenomegalia maciça (geralmente palpável a mais de 15cm de RCE) e com programação de TMO, o ideal é tentar controlar o tamanho do baço, com teoricamente benefício em taxa de enxertia. No entanto, nenhum estudo prospectivo avaliou essa abordagem.
LETRA C - INCORRETA:
Não existe nenhum protocolo específico que indique profilaxia para todos os pacientes com PMF > 65 anos, sem trombose prévia ou sem fatores de risco.
LETRA D INCORRETA e LETRA E CORRETA:
O diagnóstico é estabelecido om achados clínicos, laboratoriais, avaliação medular e avaliação de driver mutations, além de descartar outras entidades NMP como PV, TE e LMC. A realização de painel mieloide com NGS para identificar alterações moleculares (presentes em 80% dos pacientes) pode ser utilizado principalmente com objetivo de avaliar prognóstico e calcular scores prognóstico como o MIPSS70 e o MIPSS70+v2.0.
(HIAE 2018) Paciente masculino, 70 anos, assintomático, apresenta achado de poliglobulia em hemograma de rotina. Nega patologias como HAS, cardiopatia ou tabagismo. Exame físico: esplenomegalia discreta.
Hb = 18,5g/dL; Ht = 61%; leucócitos = 15.000/μL (diferencial normal); plaquetas = 500.000/mm3.
Neste caso, é INCORRETO afirmar:
(A) Na confirmação diagnóstica de PV neste paciente, o início imediato do tratamento com hidroxiureia não é necessário, pela ausência de história de trombose.
(B) Dosagem de EPO e pesquisa de mutação de Jak2 devem ser realizados.
(C) Uso de testosterona pode elevar o hematócrito.
(D) São fatores de risco para trombose na PV: Histórico de trombose prévia, idade superior a 60 anos.
(E) Na PV, a mutação do gene JAK2 (V617F) está presente em mais de 90% dos casos.
(A) Na confirmação diagnóstica de PV neste paciente, o início imediato do tratamento com hidroxiureia não é necessário, pela ausência de história de trombose.
Trata-se de um paciente de 70 anos com poliglobulia e trombocitose leve em investigação, assintomático.
A investigação desse tipo de paciente envolve descartar causas secundárias/reacionais e considerar a possibilidade de DMPCs (principalmente PV e LMC)
A suspeita de PV deve ser levantada em caso de pacientes com:
- Hb > 16,5 e Ht > 59 em homens
- Hb > 16 e Ht > 48% em mulheres
Esses valores foram atualizados em 2016. Nos critérios de 2008 os pontos de corte eram maiores e com menor sensibilidade.
Lembrar que a PV é causada por mutações do JAK2 V617F, sendo que essa mutação é encontrada em todas as células originadas em linhagem mieloide/eritroide/megacariocítica. Portanto o paciente pode se apresentar com aumento de outras séries e não apenas linhagem vermelha, como foi o caso desse paciente. Essa mutação é encontrada em 90-95% dos pacientes com PV (LETRA E CORRETA).
Uma vez levantada essa suspeita, devemos considerar a possibilidade de DMPC e descartar possíveis causas secundárias. Dentre elas, existem diversas (que geralmente são causadas por aumento reacional de EPO - LETRA B CORRETA) incluindo: Tabagismo, alterações de artérias renais, hormonoterapia (LETRA C CORRETA), neoplasias, dentre outras.
Os pacientes com PV possuem um risco mais elevado de eventos trombóticos, sejam eles venosos ou arteriais. Esses eventos são causados por aumento de viscosidade e exacerbados pela plaquetose.
O tratamento da PV é guiado pelo risco de complicações, baseando-se em:
- Idade > 60 anos
- História prévia de trombose
Caso alguns desses estejam presentes, o risco de evento trombótico se aumenta e está indicado tratamento, já que tromboses são a principal causa de morte que pode ser previnida nesses pacientes (LETRA D CORRETA)
No caso de pacientes caracterizados como alto risco pela presença de pelo menos um desses fatores, está indicado o tratamento com objetivo de redução de hematócrito, além de AAS em baixas doses. A redução de Ht pode ser feita com flebotomia ou terapia citorredutora (HU por exemplo) - LETRA A INCORRETA
(HIAE 2018) Paciente de 87 anos está em seguimento por mielofibrose (fase hipercelular) em tratamento conservador. Vem em consulta com queixa de emagrecimento, astenia, sudorese noturna e dor abdominal.
O melhor tratamento para este paciente é:
(A) Esplenectomia.
(B) Anagrelide.
(C) Prednisona.
(D) Talidomida.
(E) Ruxolitinib.
(E) Ruxolitinib.
Trata-se de uma paciente idosa de 87 anos em tratamento de MF, sendo acompanhada e com piora de sintomas constitucionais.
O tratamento de MF depende de alguns critérios, como estratificação de risco (critérios como DIPSS+ ou MIPSS-70+2.0) e pela funcionalidade e performance status, a depender a elegibilidade para TMO.
No caso de pacientes inelegíveis a TMO, sendo de alto ou baixo risco, indica-se realizar tratamento baseado no controle de sintomas. Pacientes assintomáticos (como provavelmente a paciente da questão devia ser antes) devem ser observados quanto ao surgimento de sintomas e indicação de tratamento nestes momentos. O tratamento de sintomas depende da presença de:
- Anemia apenas
- Esplenomegalia apenas
- Outros sintomas (constitucionais)
O caso da questão exemplifica a terceira opção, com paciente inelegível a TMO e com sintomas constitucionais. Nesse caso, indica-se inibidores de JAK2:
- Se plaq > 50.000 = Ruxolitinib
- Se plaq
(ASCO 2020) Mulher de 63 anos com PV JAK2+ há 20 anos se apresenta na consulta. Evoluiu para MF com dependência transfusional (CH+Plaq) 6-8 meses atras. Ao exame tem esplenomegalia sintomática que requer opioides para controle de dor. Ao hemograma Hb 6,3 Leuco 6700 com 3% blastos circulantes e Plaquetas 28.000. BxMO mostra < 5% blastos com celularidade < 10% para idade e fibrose reticulinica grau 3. Não possui irmaos e vem em uso de Jakavi por 6 meses com resposta limitada. Tem um ECOG de 0. Qual o tratamento mais apropriado?
(A) Mudar para HU 1g 2x ao dia
(B) Continuar Ruxolitinib e adicionar HU 1g 2x ao dia
(C) Buscar por doador HLA identico para TMO
(D) Realizar mobilização de células tronco e coletar > 2x106/kg
(C) Buscar por doador HLA identico para TMO
Embora terapias experimentais e convencionais aparentem ter sucesso em aliviar carga de sintomas relacionados a MF e melhorar a qualidade de vida, até agora nenhum desses tratamentos mudam o curso da doença, não impedindo progressão para transformação leucemica. Portanto, TMO alogênico permanece a única terapia potencialmente curativa em um grupo de pacientes.
No entanto, TMO é associado com importante morbimortalidade, que leva ao debate sobre quem é o melhor candidato e quando é o melhor momento para realizar o TMO.
Essa paciente desenvolveu uma MF secundária de uma longa data de PV e hoje tem importante dependência transfusional de CH e Plaquetas. Não podemos utilizar o score DIPSS plus ou MIPSS70 para avaliar sua necessidade de TMO em primeira linha, por se tratar de MF secundária. O score ideal para essa avaliação seria o MYSEC, que leva em consideração:
- Idade
- Hb < 11 (2pts)
- Plaq < 150.000 (1pt)
- Blastos > 3% (2 pts)
- CALR não mutado (2pts)
- Sintomas constitucionais (1 pt)
Essa paciente seria classificada como ALTO RISCO, pontuando em todos os aspectos. Os pacientes com MF pós PV são manejados de forma semelhante a MF primária, de modo que pacientes com alto risco e com boa PS devem ser tratadas com TMO alogênico, com a busca imediata de possíveis doadores.
Lembrar que alguns autores sugerem realizar algum manejo de esplenomegalia no pré-TMO, principalmente se palpável a 15cm de RCE. Nenhum estudo comparou prospectivamente se há beneficio, mas alguns estudos com ruxolitinib mostram taxa de enxertia mais precoce e menores taxas de recaída.
(ASCO 2020) Um homem de 73 anos encaminhado por fadiga e pancitopenia. Apresenta queixa de fadiga no ultimo ano. Apresenta atualmente dispneia aos pequenos esforços. Nega alterações ponderais ou sudorese noturna. Nega ter notado adenomegalias. Hemograma mostra:
- Hb 8,3
- Leuco 2300 (sem células anormais)
- Plaq 73.000
Ao exame fisico apresenta esplenomegalia de 10cm do RCE. Biópsia de MO mostra compatível com MF. Foi solicitado painel de mutações. Baseado na apresentação, qual das mutações é mais provável?
(A) CALR type 1 mutation
(B) JAK2 mutation in exon 14
(C) JAK2 mutation in exon 12
(D) CALR type 2 mutation
(B) JAK2 mutation in exon 14
Mutação do JAK2 V716R no exon 14 é a mutação mais comum associada a DPMC.
Mais de 90% dos pacientes vão apresentar algum driver mutation, sendo as mais comuns:
- JAK2 V617F exon 14: 60-65%
- CALR: 20-25%
- MPL: 5%
- Triplo negativo: 8-10%
Ativação constitutiva do mecanismo JAK/STAT parece importante para a patogênese de PMF.
REFERENCIAS:
Sperling AS, Gibson CJ, Ebert BL. The genetics of myelodysplastic syndrome: from clonal hematopoiesis to secondary leukaemia. Nat Rev Cancer. 2017;17(1):5-19.
Pietra D, Li S, Brisci A, et al. Somatic mutations of JAK2 exon 12 in patients with JAK2 (V617F)-negative myeloproliferative disorders. Blood. 2008;111 (3):1686-1689.
(ASCO 2020) Uma mulher de 68 anos com antecedente de DM e HAS vem para avaliação de dor abdominal e fadiga. Vem apresentando esses sintomas nos ultimos 9 meses. Ao exame físico apresenta obesidade importante e palidez cutâneo-mucosa. O hemograma mostra:
- Hb 11
- Leuco 3200 (sem células anormais)
- Plaq 75.000
USG abdominal e estudo medular foram compatíveis com MF primária. Foi realizado estudo mutacional. Qual das mutações é associada ao melhor prognóstico para essa paciente?
(A) CALR
(B) JAK2
(C) MPL
(D) Triple negative
(A) CALR
Mutação de CALR mostra maior OS em MF primária, comparado com JAK2 e MPL.
A mediana de OS muda de acordo com o perfil mutacional:
- JAK2: Mediana OS 5,9 anos
- CALR: Mediana OS 15,9 anos (melhor prognóstico)
- MPL: Mediana:OS 9,9 anos
- Triplo negativo: Mediana OS 2,3 anos (pior prognostico)
Isso pode ser exemplificado também por scores prognósticos que incluem alterações moleculares, já que no MIPSS70 ou MYSEC (para MF secundária), a ausência de mutação da CALR está associada a pior prognóstico e doença de maior risco.
REFERENCIA:
Tefferi A, Guglielmelli P, Larson DR, et al. Long-term survival and blast transformation in molecularly annotated essential thrombocythemia, polycythemia vera, and myelofibrosis. Blood. 2014;124(16):2507-2615.
(HIAE 2023) Paciente do sexo feminino, 45 anos, previamente rígida, apresenta prurido após banhos e dor em palmas de mãos. Hemograma:
- Hb 17
- Ht 55%
- Leuco 11.200 (Neu 8.000)
- Plaq 320.000
- EPO reduzida
MO: Hipercelularidade nas 3 séries com megacariócitos maduros. Exame de JAK em andamento. Sobre esse caso é correto afirmar
(A) EPO reduzida afasta o diagnóstico de PV
(B) É importante investigar causas secundárias de poliglobulia como hipóxia e monitorizar, visto que para o diagnóstico de PV é necessário Hb maior ou igual a 18
(C) Segundo a WHO, é necessário JAK2 V617F ou exon12 mutado para confirmação diagnóstica
(D) O tratamento deverá ser realizado com sangrias e AAS
(D) O tratamento deverá ser realizado com sangrias e AAS
LETRA A INCORRETA: A PV é uma DMPC causada pela mutação do JAK2 V617F resultando em estímulo de proliferação medular. Isso resulta em possível elevação em células das 3 linhas e a principal manifestação clínica é a poliglobulia. Pela elevação na série vermelha, ocorre uma supressão por feedback negativo na produção de EPO, de modo que EPO em níveis reduzidos fala a favor de PV e não de causas secundárias.
LETRA B INCORRETA: O diagnóstico de PV deve ser suspeitado a partir de níveis de Hb > 16,5 (Ht 49%) em homens e > 16 em mulheres (Ht 48%). Antigamente o nível para levantar a suspeita era maior, o que levava muitos pacientes a serem caracterizados como outra DMPC JAK2 positivo. Essa mudança de diminuir o corte foi realizada com objetivo de aumentar a sensibilidade. Além disso, causas de polioglobulia secundárias (como hipóxia) são afastadas no caso dessa paciente, tendo em vista a EPO reduzida, que sugere uma doença primária da MO.
LETRA C INCORRETA: O critério diagnóstico de PV depende da obtenção de critérios maiores e menores
- Maiores:
1. Hb > 16 (Ht > 48) em mulheres e Hb > 16,5 (Ht > 49) em homens
2. MO compatível
3. JAK 2 V617F ou exon 12 positivo
- Menor:
1. EPO reduzida
O diagnóstico é estabelecido se os 3 critérios maiores estiverem presentes ou se 2 critérios maiores ou um menor. Ou seja, apesar de 95% dos casos de PV ter a mutação, ainda é possível estabelecer o diagnóstico de PV
_LETRA D CORRETA_: Trata-se de um paciente com PV de baixo risco, tendo em vista idade inferior a 65 anos e ausência de histórico pessoal de trombose. O tratamento deve incluir flebotomias para atingir Ht < 45 e AAS em baixas doses.
Em que cenário podemos realizar o diagnóstico de um paciente com suspeita de PV sem realizar estudo medular?
O critério diagnóstico de PV depende da obtenção de critérios maiores e menores
O diagnóstico é estabelecido se os 3 critérios maiores estiverem presentes ou se 2 critérios maiores ou um menor.
Dessa forma, caso o paciente tenha poliglobulia com JAK positivo e EPO consumida, o estudo medular não é necessário para o diagnóstico. No entanto, idealmente os níveis de poliglobulia devem ser maiores e sustentados para evitar estudo medular:
- Homem: Hb > 18,5 Ht > 55,5
- Mulher: Hb > 16,5 Ht > 49,4
Levar em consideração que avaliação de medula sempre é util em avaliar celularidade e grau de fibrose da MO, avaliando um possível risco de progressão.
(DASA 2022) Assinale a alternativa INCORRETO sobre as Hipereosinofília.
(A) A Hipereosinofilia é definida pela presença de mais de 1500 eosinófilos por mm³ no sangue periférico ou nas seguintes
condições: infiltração patológica de tecidos por eosinófilos; > 20% de eosinófilos das células nucleadas na medula óssea por
mielograma; deposição acentuada de proteínas de eosinófilos nos tecidos.
(B) A Hipereosinofilia subtipo linfócito-variante geralmente apresenta curso agressivo, com prognóstico desfavorável, devendo
considerar o TMO alogênico como tratamento definitivo nestes casos.
(C) A hipereosinofilia com mutação no FIP1L1-PDGFRA, tem uma ótima resposta com doses baixas de imatinibe (100 mg). Com
variantes da mutação do PDGFRB e PDGFRA, o uso do imatinibe deve ser aumentado para 400 mg e mantém uma ótima resposta molecular, em torno de 96%.
(D) A hipereosinoflia associada a anormalidade do FGFR1 e PCM jak2, geralmente evolui para LMA em 1-2 anos. Não há consenso
quanto ao tratamento ideal para tais casos, porém a maioria dos pacientes apresentam resistência a quimioterapia, devendo
considerar o TMO alogênico como tratamento definitivo.
(B) A Hipereosinofilia subtipo linfócito-variante geralmente apresenta curso agressivo, com prognóstico desfavorável, devendo
considerar o TMO alogênico como tratamento definitivo nestes casos
Eosinofilia leve (definida por contagem de eosinofilos entre 500-1000) é comum, ocorrrendo em 3-10% dos indivíduos a depender da população estudada. Causas frequentes incluem: Doença atópica, hipersensibilidade e infecção helmintica.
Ao contrário, hipereosinofilia é definida pela contagem de eosinofilos > 1500 e é relativamente raro, devendo nesses casos ser realizada investigação de causas e de possíveis complicações de órgão alvo por deposição de eosinofilos. A deposição de eosinófilos em tecidos é o evento definidor das síndromes hipereosinofilicas e pode ser caracterizado como:
- Infiltração > 20% eosinofilos na MO
- Infiltração tecidual por eosinófilos por biópsia
- Intensa deposição extravascular de proteínas derivadas de eosinófilos nos tecidos evidenciado por imunohistoquimica
(LETRA A CORRETA)
Nos consensos de diagnóstico de tratamento de síndrome hipereosinofiilica, desde 2005 e atualizado em 2010, foi proposto um esquema que subdivide os pacientes com síndrome hipereosinofilica em 6 subgrupos:
- HES mieloproliferativa
- HES linfócito variante
- HES overlap
- HES secundária
- HES familiar
- HES idiopática
HES MIELOPROLIFERATIVA
Subgrupo de pacientes com HES que se apresentam com fenótipo de DMPC, com B12 elevado, anormalidades cromossômicas, anemia/plaquetopenia, hepatoesplenomegalia ou precursores mieloides circulantes.
Trata-se de uma doença clonal mieloproliferativa e com boa resposta ao tratamento com imatinib. A maioria desses pacientes apresentam alteração no cromossomo 4q12 causando a ativação contínua de uma tirosina quinas FIP1L1-PDGFRA que pode ser detectado por FISH ou PCR. Outras alterações moleculares também são descritas mas incomuns (KIF5B-PDGFRA, ETV6-PDGFRB, PCM1-JAK2). Em geral essas formas variantes apresentam pior desfecho e piores respostas a ITK, de modo que existem algumas demonstrações que doses menores de imatinib como 100mg podem induzir a melhora clinica e laboratorial (LETRA C CORRETA), mesmo que doses baixam sejam ineficazes em manter resposta molecular.
A mutação PMC1-JAK2 é muito rara e o seu tratamento ideal ainda é desconhecido. Até o momento, indica-se inibidores de JAK e TMO (LETRA D CORRETA)
HES LINFOCITO-VARIANTE
Caracterizado pelo envolvimento de pele e partes moles, embora possa apresentar outras manifestações de lesão de órgão alvo pela eosinofilia. Apresenta linfocitos aberrantes clonais, geralmente CD3- e CD4+ que secretam IL-5 e aumentam produção de IgE. Pode se apresentar com linfadenopatia e pode evoluir para linfoma em até 25% dos casos. Tipicamente tem um curso INDOLENTE, com uma possível progressão ocorrente depois de anos (LETRA B INCORRETA)
O que caracteriza a síndrome de Gleich?
A síndrome de Gleich também é conhecida como Angioedema Episódico com Eosinofilia. Compreende um subgrupo de pacientes com síndrome hipereosinofílica linfócito-variante que se apresenta com episódios cíclicos de angioedema e urticária que ocorrem a cada 28-32 dias e são acompanhados de elevações em IL-5 séricas e eosinofilia importante. Os sintomas e alterações laboratoriais se resolvem espontaneamente no período entre os ciclos.
(AC 2023) Os valores mínimos aceitáveis de Hb e de Ht são:
- Hb = 12,5g/dL ou Ht = 38% para mulheres e Hb = 13,0g/dL ou Ht = 39%, para homens.
Assinale a alternativa que apresenta os valores máximos aceitos de Hb e de Ht:
(A) Não há limite máximo nem para homens nem para mulheres.
(B) Hb ≥ 16,5 ou Ht ≥ 54% para homens ou Hb ≥ 16,0 e Ht ≥ 48% para mulheres.
(C) Hb ≥ 18,0 ou Ht ≥ 52% para homens ou Hb ≥ 16,0 e Ht ≥ 47% para mulheres, se saturação > 92%.
(D) Hb ≥ 18,0 ou Ht ≥ 54% para homens e mulheres.
(E) Hb ≥ 18,5 ou Ht ≥ 55% para homens ou Hb ≥ 16,5 e Ht ≥ 49% para mulheres.
(B) Hb ≥ 16,5 ou Ht ≥ 54% para homens ou Hb ≥ 16,0 e Ht ≥ 48% para mulheres
O diagnóstico de doenças mieloproliferativas (dentre elas a PV) deve ser suspeitado de acordo com o hemograma. O grau de policitemia que indica a suspeita é:
- Homem: Hb > 16,5 ou Ht 49%
- Mulher: Hb > 16 ou Ht > 48%
Os valores de corte foram atualizados na ultima classificação em 2016. Nos critérios anteriores de 2008 os pontos de corte eram maiores e tinham menos sensibilidade ao diagnóstico. Estudos mostravam que muitos pacientes com TE JAK2 positiva com trombocitose e Ht mais baixos eram reclassificados como PV quando realizados estudos de MO ou massa eritrocitária.
Dessa forma, a alternativa que mais se aproxima desse valor é a LETRA B, mas mesmo assim não é completamente correta. Por isso a questão foi anulada corretamente
(AC 2023) A eosinofilia pode estar relacionada a diversas situações reacionais e a doenças hematológicas agudas ou crônicas, tornando sua investigação bastante laboriosa quando não imediatamente relacionada à verminose ou a quadro alérgico. Com o maior acesso às pesquisas mutacionais fica mais comum a determinação de algum diagnóstico clonal, tornando cada vez mais raro o achado de síndrome hipereosinofílica. A partir dessas informações, assinale a alternativa que indica alteração importante na sequência diagnóstica das patologias clonais eosinofílicas:
(A) SOX-11
(B) EBV
(C) PDGFRα
(D) t(8:21)
(E) SF3B1
(C) PDGFRα
Eosinofilia leve é definida como contagem absoluta de eosinófilos entre 500-1000 e é comum ocorrendo em até 10% da população. Causas frequentes incluem atopia, asma e infecção helmintica.
Ao contrário hipereosinofilia é definida como contagem absoluta de > 1.500 e é relativamente raro, sendo necessária investigação da sua causa e pesquisa de manifestações de órgão alvo. O acometimento tecidual é o definidor de SÍNDROMES HIPEREOSINOFÍLICAS e esse acometimento é definido como:
- > 20% de eosinófilos em relação a outras células nucleadas na MO
- Infiltração de outros tecidos na biópsia que na opinião do patologista encontra marcadamente aumentado
- Deposição extracelular importante de proteínas derivadas de eosinófilos pela IHQ
Síndromes hiperosinofílicas, de qualquer causa, são potencialmente ameaçadoras a vida, com complicações como envolvimento cardíaco, TEV e manifestações neurológicas. Sinais clínicos e laboratoriais associados a pior desfecho incluem:
- Leuco > 100.000
- Sinais de IX
- Outros achados sugestivos de DMPC (esplenomegalia, desvio a E no SP, B12 elevada)
- Resistencia a corticoterapia
Em 2005 um consenso para tratamento de HES propos um esquema de classificação que subdividia esses pacientes de acordo com caracteristicas clínicas. Essa classificação foi refinada em 2010 e divide os pacientes em 6 variantes clínicas
- HES mieloproliferativa
- HES variante linfocítica
- HES overlap
- HES associada
- HES familair
- HES idiopática
Dentre esses pacientes, destacam-se o do grupo de doença mieloproliferativa. Principalmente porque nesses pacientes o uso de ITK pode ser uma opção no tratamento. A maioria dos pacientes respondedores a Imatinib possuem uma alteração do cromossomo 4, causando uma tirosina quinase constitutivamente ativa FIP1L1-PDGRFA que pode ser detectada por FISH em SP ou MO - LETRA C CORRETA.
Outras fusões menos comuns são:
- KIF5B-PDGFRA
- ETV6-PDGFRB
Esses pacientes com documentação de mutações devem ser tratados com Imatinib 100-400mg/dia. Corticoides devems er administrados durante os primeiros duas de imatinib nos pacientes com história de envovimento cardíaco ou troponina elevada para prevenir necrose miocárdica (uma complicação rara do uso de imatinib em pacientes com eosinofilia. A resposta a imatinib geralmente vem em dias a semanas e quase todos os pacientes apresentam resposta hematológica e molecular. Tento em vista que a presença da mutação FIP1L1-PDGRFA acontece antes do retorno da eosinofilia e dos sintomas, os pacientes devem ser vigiados a cada 3-6 meses durante Imatinib e após a descontinuação.